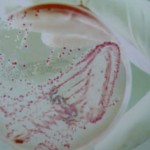

Nasi studenci z klas IV, tym razem uczestniczyli w zajęciach na terenie szkoły. Absolwentki Wydziału Analityki Uniwersytetu Medycznego przygotowały dla nich niezwykle atrakcyjne warsztaty: dzieci obserwowały bakterie, uczyły się posługiwać sprzętem laboratoryjnym, rozpoznawały składniki krwi. Najwięcej atrakcji wzbudziły ćwiczenia (oczywiście teoretyczne!) w pobieraniu krwi do badań laboratoryjnych.
Panie były autentycznie zaskoczone, jak ogromną wiedzę medyczną posiadają nasi czwartoklasiści. Miło mi Państwa o tym poinformować!
Wiesława Ciuksza
opublikowano: 29.03.2017